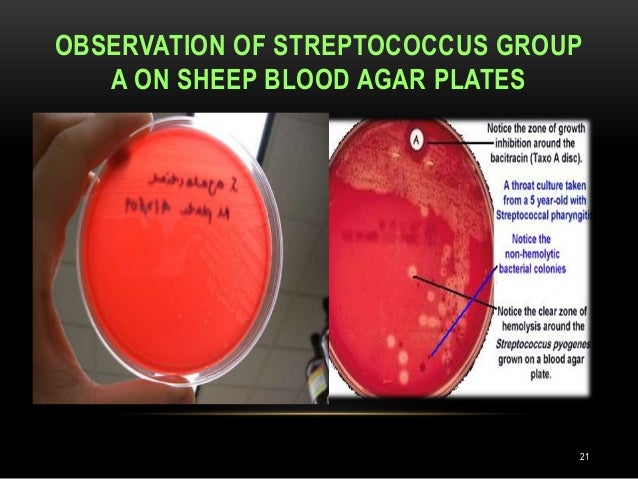

Adult in recurrent strep throat
Recurring Strep Throat

Why Your Strep Throat Keeps Coming Back

The parent’s guide to strep throat in kids

Antibiotics for preventing recurrent sore throat


Recurring Strep Throat: Causes, Treatment Options and Prevention
NICE has recommended that for people with severe recurrent tonsillitis a frequency of more than seven episodes per year for one year, five per year for two years, or three per year for three years, and for whom there is no other explanation for the recurrent symptoms , referral to an ear, nose, and throat specialist is advised as there may be a benefit from tonsillectomy in this group.. Keep your children away from secondhand smoke.

She's no angel, Bonnie Rotten, grows upwardly togetherwith becomes a little slut...
Description: Ashley i deep throat. Deep throat sex instructions.
Views: 8568
Date: 30.10.2019
Favorited: 43


































User Comments 3
Post a comment
Comment: